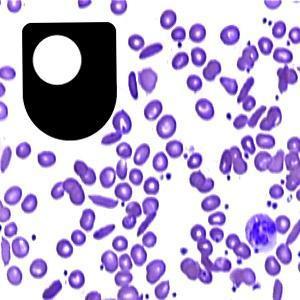
Sickle cell disease: a lethal advantage - for iPad/Mac/PC by The Open University

Sign up to save your podcasts
Or


By The Open University
4.7
33 ratings
The podcast currently has 14 episodes available.
The podcast currently has 14 episodes available.

170 Listeners

3 Listeners

13 Listeners

16 Listeners

0 Listeners

103 Listeners

33 Listeners

61 Listeners

8 Listeners
11 Listeners